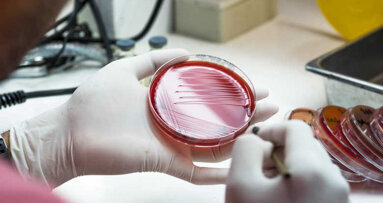
Badania nad siłą systemów obronnych organizmu

Istnieje wyraźny związek pomiędzy wadami zgryzu a równowagą, stabilnością i postawą ciała – udowodnili badacze z krakowskich uczelni. Dlatego lecząc i diagnozując wady postawy, należy spojrzeć na pacjenta holistycznie, a nie tylko przez pryzmat układu kostnego i mięśniowego.
Postawa ciała, czyli jego charakterystyczne ułożenie i zorientowanie w przestrzeni silnie zależy od struktury, funkcji i współpracy mięśni, powięzi, szkieletu i układu nerwowego. Utrzymanie stabilnej pozycji stojącej jest możliwe dzięki precyzyjnej koordynacji wszystkich tych systemów oraz ciągłej analizy napływających bodźców.
Od lat w środowisku naukowym toczy się debata na temat tego, jak dużą rolę w utrzymywaniu stabilności postawy odgrywa układ czaszkowo-żuchwowy, w tym budowa zgryzu. Temat ten nadal budzi wiele kontrowersji, ponieważ wyniki badań nie są spójne: niektóre potwierdzają, inne obalają teorię o istnieniu korelacji pomiędzy narządem żucia a postawą.
W związku z tym zespół dr Moniki Nowak z Wydziału Lekarskiego i Nauk o Zdrowiu Krakowskiej Akademii im. Andrzeja Frycza Modrzewskiego postanowił ocenić wpływ wad zgryzu przednio-tylnego na kontrolę postawy i rozkład nacisku podeszwowego podczas stania i chodzenia. Wyniki swoich ustaleń naukowcy opisali na łamach czasopisma „International Journal of Environmental Research and Public Health”.
Wady zgryzu często są wrodzone i mogą wynikać z czynników dziedzicznych lub środowiskowych. Jednak ich przyczyną mogą być także: nieprawidłowy rytm oddychania, wady postawy, obgryzanie paznokci czy bruksizm. Wg szacunków, nieprawidłowy zgryz dotyczy ok. 56% populacji. Chociażby z tego względu analiza poszczególnych wad i towarzyszących im zaburzeń narządu ruchu jest jak najbardziej zasadna.
Do badania zespół dr Nowak zakwalifikował 90 zdrowych ochotników w wieku 19-35 lat, których podzielił na 3 grupy w zależności od budowy zgryzu, a dokładnie od klasy okluzji, czyli pozycji stykania się zębów górnych z dolnymi. Grupę pierwszą stanowiły osoby ze zgryzem prawidłowym (I klasą w klasyfikacji Angle’a), grupę drugą osoby z tyłozgryzem (II klasa Angle’a), a trzecią – z przodozgryzem (III klasa Angle’a). Następnie naukowcy oceniali postawę ciała uczestników, w tym stabilność, równowagę, obciążenie stóp i chód.
Okazało się, że między osobami z 3 grup badawczych występowały bardzo wyraźne różnice, np. ludzie z tyłozgryzem mieli tendencję do przesunięcia środka nacisku stóp do przodu w porównaniu do pozostałych grup, a zarówno tyło-, jak i przodozgryz wiązały się z wyraźnie zmienionymi wynikami różnych testów posturalnych. Jednym słowem: okluzja miała wpływ na statyczną stabilność postawy, a pacjenci z jej zaburzeniami charakteryzowali się gorszą stabilnością i tendencją do przesuwania środka ciężkości.
„Różne obszary ciała są połączone poprzez łańcuchy mięśniowo-powięziowe oraz struktury nerwowe” – wyjaśnia dr Nowak. „Dlatego każda zmiana w obrębie układu stomatognatycznego (np. wada zgryzu), wpływająca na biomechanikę stawu skroniowo-żuchwowego może generować zmiany napięcia mięśni żucia oraz bezpośrednio z nimi powiązanych mięśni szyi. Następnie, poprzez łańcuchy mięśniowo-powięziowe zmiany te mogą być przenoszone na dalsze mięśnie, nawet te z obszaru miednicy i kończyn dolnych” – dodaje. Poza tym, jak tłumaczy dr Monika Nowak, w wyniku niezrównoważonego stykania się zębów górnych i dolnych dochodzi do zaburzeń w odbieraniu sygnałów przez proprioreceptory przyzębia, odpowiadające za tzw. czucie głębokie i różnorakie napięcia mięśniowe. Nieprawidłowości te zakłócają informacje nerwowe przekazywane do mózgu, co wpływa m.in. na zaburzenie funkcji gałek ocznych i mięśni obręczy barkowej, a to z kolei, po wyczerpaniu mechanizmów kompensacyjnych, poprzez mięśnie i powięź rzutuje na niższe segmenty ciała.
Zarówno omawiane badanie, jak i kilka wcześniejszych są dowodem na to, że związek między wadami zgryzu a zaburzeniami postawy istnieje. Sami dentyści coraz częściej dostrzegają potrzebę współpracy z fizjoterapeutami – bez tego prowadzone przez nich leczenie ortodontyczne może nie przynosić zadowalających efektów.
Zdaniem dr Nowak, do każdego pacjenta trzeba więc podchodzić holistycznie: nie skupiać się na jednym układzie, ale patrzeć szerzej, bo całe ciało jest siecią wzajemnych powiązań. „Leczenie ortodontyczne może stanowić ważną część profilaktyki nieprawidłowości postawy oraz dolegliwości bólowych w obrębie narządu żucia i całego narządu ruchu, a przez to zapobiegać kontuzjom” – zaznacza badaczka.
Jest to o tyle istotne, że obecnie wady zgryzu dotyczą nawet 79% polskich dzieci. „Zajęcie się tym problemem w odpowiednim czasie znacznie zmniejszy ryzyko występowania tego, co często obserwuję w gabinecie fizjoterapeutycznym, czyli tzw. zaburzeń zstępujących. Jest to sytuacja, w której nieprawidłowości w górnych partiach ciała rzutują niekorzystnie na obszary usytuowane niżej. Przywrócenie stabilnych warunków w obszarze czaszkowo-żuchwowym może więc stanowić początek przywrócenia zsynchronizowanego funkcjonowania całego narządu ruchu” – tłumaczy dr Nowak. „Tylko międzydyscyplinarna współpraca specjalistów przyczynia się do efektywnego wyeliminowania zaistniałych deficytów” – podsumowuje.
źródło: Nauka w Polsce
Polacy nie czytają etykiet umieszczanych na produktach spożywczych – wynika z badań konsumenckich przeprowadzonych przez Instytut Żywności i ...
Jeśli masz wadę zgryzu, grozi ci przyspieszone starzenie. Złym zgryzem szybciej niż rówieśnicy zapracujesz na zmarszczki i bruzdy, opadające ...
Wypełnienie ubytku po próchnicy musi precyzyjnie naśladować pierwotny kształt zęba. Za niska i płaska plomba zepsuje zgryz, może ...
Oporność na antybiotyki staje się coraz ważniejszym problemem w stomatologii, medycynie i zdrowiu publicznym. Ponieważ nadmierne przepisywanie ...
The Dawson Academy, renomowany ośrodek edukacji podyplomowej dla stomatologów, uruchomił nowy kampus online i otworzył rejestrację na inauguracyjny ...
Choć procesu starzenia się organizmu nie można powstrzymać, można go spowolnić. Wg naukowców, nasz wygląd i kondycja fizyczna zależy nie tylko od ...
Naukowcy zidentyfikowali składnik chemiczny obecny w granatach, który można uznać za klucz do długowieczności. Badacze ze Szwajcarii wyizolowali...
Krzywe zęby nie tylko wyglądają źle w uśmiechu. Dentyści zauważają, że nieprawidłowy zgryz wpływa na wygląd całej twarzy. U prawie 80% ...
Wirusy mogą wykorzystywać informacje zebrane ze środowiska, aby zdecydować, czy „siedzieć cicho” w swoim gospodarzu, czy zacząć się namnażać ...
Już po raz trzeci Targi CEDE wspierały niezwykłe dzieło pomocy niepełnosprawnym i najciężej chorym dzieciom, jakie prowadzi NZOZ Stomatologia ...
Webinarium na żywo
czw. 25 czerwca 2026
8:00 (CET) Warsaw
Dr. Hatem Algraffee, Cat Edney
Webinarium na żywo
wto. 30 czerwca 2026
5:00 (CET) Warsaw
Webinarium na żywo
wto. 30 czerwca 2026
7:30 (CET) Warsaw
Prof. Dr. Anahita Jablonski-Momeni
Webinarium na żywo
śro. 1 lipca 2026
2:00 (CET) Warsaw
Linda Hecker MS, BSDH, RDH
Webinarium na żywo
śro. 1 lipca 2026
2:00 (CET) Warsaw
Webinarium na żywo
czw. 2 lipca 2026
5:00 (CET) Warsaw
Dr. Albéric Santamaria-Loisy
Webinarium na żywo
czw. 2 lipca 2026
8:00 (CET) Warsaw



 Austria / Österreich
Austria / Österreich
 Bośnia i Hercegowina / Босна и Херцеговина
Bośnia i Hercegowina / Босна и Херцеговина
 Bułgaria / България
Bułgaria / България
 Chorwacja / Hrvatska
Chorwacja / Hrvatska
 Czechy i Słowacja / Česká republika & Slovensko
Czechy i Słowacja / Česká republika & Slovensko
 Francja / France
Francja / France
 Niemcy / Deutschland
Niemcy / Deutschland
 Grecja / ΕΛΛΑΔΑ
Grecja / ΕΛΛΑΔΑ
 Węgry / Hungary
Węgry / Hungary
 Włochy / Italia
Włochy / Italia
 Holandia / Nederland
Holandia / Nederland
 nordycki / Nordic
nordycki / Nordic
 Polska / Polska
Polska / Polska
 Portugalia / Portugal
Portugalia / Portugal
 Rumunia i Mołdawia / România & Moldova
Rumunia i Mołdawia / România & Moldova
 Słowenia / Slovenija
Słowenia / Slovenija
 Serbia i Czarnogóra / Србија и Црна Гора
Serbia i Czarnogóra / Србија и Црна Гора
 Hiszpania / España
Hiszpania / España
 Szwajcaria / Schweiz
Szwajcaria / Schweiz
 indyk / Türkiye
indyk / Türkiye
 Wielka Brytania i Irlandia / UK & Ireland
Wielka Brytania i Irlandia / UK & Ireland
 Międzynarodowy / International
Międzynarodowy / International
 Brazylia / Brasil
Brazylia / Brasil
 Kanada / Canada
Kanada / Canada
 Ameryka Łacińska / Latinoamérica
Ameryka Łacińska / Latinoamérica
 USA / USA
USA / USA
 Chiny / 中国
Chiny / 中国
 Indie / भारत गणराज्य
Indie / भारत गणराज्य
 Pakistan / Pākistān
Pakistan / Pākistān
 Wietnam / Việt Nam
Wietnam / Việt Nam
 ASEAN / ASEAN
ASEAN / ASEAN
 Izrael / מְדִינַת יִשְׂרָאֵל
Izrael / מְדִינַת יִשְׂרָאֵל
 Algieria, Maroko i Tunezja / الجزائر والمغرب وتونس
Algieria, Maroko i Tunezja / الجزائر والمغرب وتونس
 Bliski Wschód / Middle East
Bliski Wschód / Middle East

To post a reply please login or register